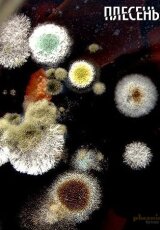
Плесень. Есть ли шансы у человечества?
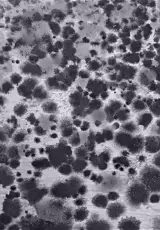
Черная плесень — страшилка или реальная угроза?

Плесень - документальные
Подборка документальных фильмов про плесень открывает завесу тайн над миром микроскопических организмов. Узнайте о различных видах плесени, их роли в природе и влиянии на окружающую среду. Исследуйте процессы роста и распространения этих микроорганизмов, а также их значение в медицине и промышленности. Погрузитесь в загадочный микромир, где царят грибы и бактерии, формирующие уникальные экосистемы.